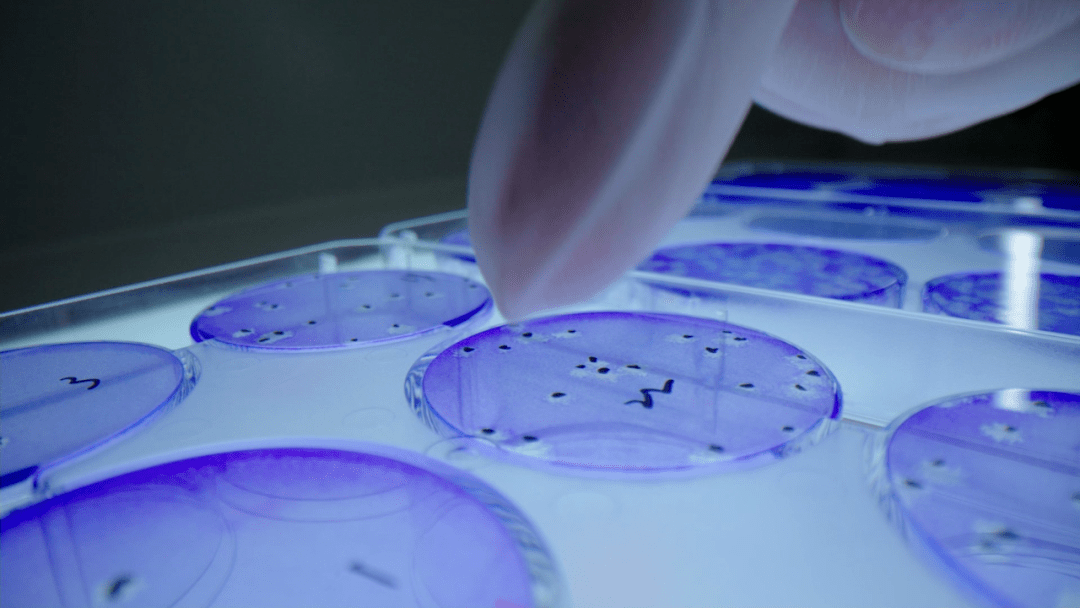
龙建股份：围绕主业向产业链上下游延伸，探索新能源、新材料等新赛道

(原标题:龙建股份:围绕主业向产业链上下游延伸,探索新能源、新材料等新赛道)
图片来源于网络,如有侵权,请联系删除
龙建股份(600853)9月15日召开2025年半年度业绩说明会,针对公司2025年半年度经营成果、财务状况,公司管理层主要成员与投资者进行互动交流和沟通。

图片来源于网络,如有侵权,请联系删除
龙建股份主要从事公路工程、市政道路桥梁等施工及咨询设计,以及相关基础设施投资、运维、养护和管理等工作。公司是东北地区最具实力、最具规模的大型基础设施建设综合服务商之一,在黑龙江省有稳定的市场份额,并且正在积极拓展其他省份及海外市场,发展足迹遍布国内31个省、自治区、直辖市和国外23个国家。公司在大股东建投集团整体发展中具有举足轻重的地位,是建投集团改革发展的重要“压舱石”和“排头兵”。
据龙建股份2025年半年度报告,报告期内,公司实现营业收入50.83亿元,实现利润总额1.02亿元,实现归属于上市公司股东的净利润6993.57万元,期末资产总额354.42亿元,归属于母公司所有者权益37.84亿元。
龙建股份在半年报中介绍,2025年上半年,公司在重点项目攻坚突破、多元业务拓展等方面取得了积极进展,实现新增合同订单70.24亿元。其中,省内业务紧跟省厅及各地市重点交通工程建设,成功中标多个项目;同时集中优势资源攻坚省内主责区域,县域市场成果显著。省外市场通过紧密对接与积极争取,投资类项目取得重要突破,股权多元化公司建设收获阶段性成果,空白区域开拓初见成效,新能源基础设施建设也取得一定进展。
“受全国建筑业下行影响,省内外招标项目数量减少,公司订单规模有所下滑。公司四季度重点关注省内吉黑高速公路项目、国道京漠公路加格达奇至瓦拉干段项目、国省道养护工程项目等,市场开发各项工作均在有序推进。”龙建股份表示,公司实施的项目以政府投资项目为主,项目实施风险可控,在建项目均可不同程度为公司贡献收入和利润。
据龙建股份介绍,公司面临的应收账款清收问题,在建筑行业中具有一定的普遍性,受项目周期、结算流程、工程验收等因素影响,导致应收账款金额较大、回收周期较长;公司通过建立督办机制,加强日常催收与管控,强化回款考核;把握当前政府化解债务风险契机,积极跟进化债方案落实,实现清收回款。
未来,公司将紧密跟踪国家和黑龙江省经济社会发展大局,关注重大交通工程、重大市政工程等基础设施建设及发展海外业务。并且,公司在“十五五”期间聚焦主业的同时,围绕主业向产业链上下游延伸,探索新能源、新材料、节能环保等新赛道。
另外,公司目前没有正在跟踪的冰雪项目,后续将持续关注黑龙江省内冰雪领域项目规划。
